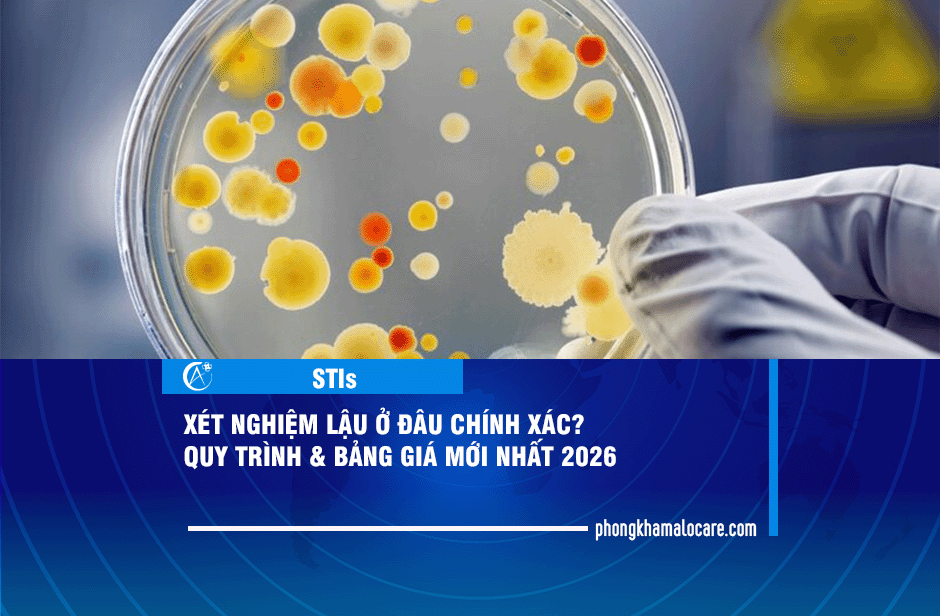
xét nghiệm lậu

PrEP Đồng Chi Trả Đa Bậc: Giải Pháp Dự Phòng HIV Linh Hoạt Từ ALO CARE
 10/04/2026
10/04/2026
 2:41:43 Chiều
2:41:43 Chiều
Sử dụng PrEP (Dự phòng trước phơi nhiễm HIV) là cách hiệu quả nhất để bảo vệ bản thân khỏi nguy cơ lây nhiễm HIV lên đến 99%. Tuy nhiên, chi phí xét nghiệm đầu vào và theo dõi định kỳ đôi khi trở thành rào cản khiến nhiều bạn chần chừ. Thấu hiểu điều […]
Kiêng gì và ăn gì để hết sùi mào gà? Bí quyết kiểm soát virus HPV hiệu quả
 05/04/2026
05/04/2026
 4:39:18 Chiều
4:39:18 Chiều
Sùi mào gà là bệnh lây truyền qua đường tình dục do virus HPV gây ra. Một trong những đặc tính “khó chịu” nhất của loại virus này là khả năng tái phát nếu hệ miễn dịch suy yếu. Bên cạnh việc điều trị y tế tại phòng khám, nhiều người thắc mắc: Ăn gì […]
Phân biệt Chuỗi hạt ngọc dương vật và Sùi mào gà: Dấu hiệu và Cách xử lý đúng
 03/04/2026
03/04/2026
 4:23:56 Chiều
4:23:56 Chiều
Nhiều nam giới khi phát hiện các nốt nhỏ quanh dương vật thường rơi vào trạng thái “mất ăn mất ngủ” vì lo lắng. Thực tế, có đến 30% nam giới gặp phải tình trạng Chuỗi hạt ngọc – một hiện tượng sinh lý hoàn toàn lành tính, nhưng lại rất dễ bị nhầm lẫn […]
Xét nghiệm STIs định kỳ bao nhiêu tiền? Gói khám chuyên biệt cho cộng đồng LGBT+
 19/03/2026
19/03/2026
 1:53:18 Chiều
1:53:18 Chiều
Trong hành trình chăm sóc sức khỏe tình dục, việc chủ động tầm soát không chỉ là bảo vệ bản thân mà còn là trách nhiệm với bạn tình. Tuy nhiên, rào cản về chi phí và sự riêng tư thường khiến nhiều người trì hoãn. Vậy xét nghiệm STIs định kỳ bao nhiêu tiền […]
Các phương pháp điều trị sùi mào gà phổ biến: Cách nào hiệu quả, ít tái phát?
 13/03/2026
13/03/2026
 1:35:53 Chiều
1:35:53 Chiều
Sùi mào gà là nỗi ám ảnh đối với nhiều người bởi tính chất dễ lây lan và tỷ lệ tái phát cao. Câu hỏi lớn nhất mà khách hàng thường đặt ra cho ALO CARE là: “Điều trị sùi mào gà bằng cách nào hiệu quả nhất?” và “Làm sao để không bị lại?”. […]
Top 5 bệnh STIs thường bùng phát sau Tết: Dấu hiệu & Cách xử lý nhanh
 26/02/2026
26/02/2026
 5:32:46 Chiều
5:32:46 Chiều
Kỳ nghỉ Tết là thời gian của những buổi tiệc tùng, du lịch và những mối quan hệ mới. Tuy nhiên, đây cũng là thời điểm các cơ sở y tế ghi nhận số ca mắc STIs (bệnh lây truyền qua đường tình dục) tăng vọt. Do tâm lý chủ quan hoặc ảnh hưởng của […]
Dấu hiệu sùi mào gà: Nhận biết sớm để điều trị kịp thời, tránh biến chứng
 01/02/2026
01/02/2026
 2:43:50 Chiều
2:43:50 Chiều
Dấu hiệu sùi mào gà thường xuất hiện âm thầm, không gây đau hay ngứa trong giai đoạn đầu khiến nhiều người chủ quan. Việc phát hiện muộn không chỉ gây khó khăn cho điều trị mà còn tiềm ẩn nguy cơ ung thư cổ tử cung, dương vật và vòm họng. Bài viết dưới […]
Tầm soát 13 tác nhân gây bệnh tình dục: Bảo mật, Chính xác tại ALO CARE
 28/01/2026
28/01/2026
 4:30:44 Chiều
4:30:44 Chiều
Các bệnh lây truyền qua đường tình dục (STDs) đang có xu hướng gia tăng và trẻ hóa nhanh chóng. Đáng lo ngại nhất là nhiều mầm bệnh tồn tại âm thầm, không triệu chứng, dễ lây lan cho bạn đời. Tầm soát 13 tác nhân gây bệnh tình dục là giải pháp toàn diện […]
Viêm gan B: Chủ động để phát hiện sớm
 26/01/2026
26/01/2026
 2:40:06 Chiều
2:40:06 Chiều
Viêm gan B là một trong những bệnh truyền nhiễm phổ biến và nguy hiểm hàng đầu tại Việt Nam. Bệnh thường tiến triển “thầm lặng” nhưng có thể dẫn đến xơ gan hoặc ung thư gan. Bài viết sau đây sẽ cung cấp đầy đủ kiến thức về virus HBV và giải pháp bảo […]
Triệu chứng giang mai qua 4 giai đoạn và cách nhận biết sớm nhất
 20/01/2026
20/01/2026
 4:20:45 Chiều
4:20:45 Chiều
Giang mai là bệnh lây truyền qua đường tình dục nguy hiểm do xoắn khuẩn Treponema pallidum gây ra. Bệnh tiến triển âm thầm qua nhiều thời kỳ với các dấu hiệu khác nhau. Việc nhận biết sớm triệu chứng giang mai giúp bạn điều trị kịp thời, bảo vệ nội tạng và sức khỏe […]
Xét nghiệm các bệnh lây truyền qua đường tình dục (STIs) ở đâu, giá bao nhiêu?
 16/01/2026
16/01/2026
 3:35:12 Chiều
3:35:12 Chiều
Các bệnh lây truyền qua đường tình dục (STIs) đang có xu hướng gia tăng và thường diễn tiến âm thầm. Việc xét nghiệm các bệnh lây truyền là giải pháp then chốt giúp phát hiện sớm, điều trị kịp thời và ngăn ngừa biến chứng nguy hiểm như vô sinh hay ung thư. Bài […]
Xét nghiệm lậu ở đâu chính xác? Quy trình & Bảng giá mới nhất 2026
 10/01/2026
10/01/2026
 4:18:50 Chiều
4:18:50 Chiều
Xét nghiệm lậu là phương pháp duy nhất để xác định sự hiện diện của vi khuẩn Neisseria gonorrhoeae. Việc phát hiện sớm không chỉ giúp bảo vệ sức khỏe sinh sản mà còn ngăn ngừa các biến chứng nguy hiểm như viêm vùng chậu hay vô sinh. Nếu bạn đang có dấu hiệu nghi […]